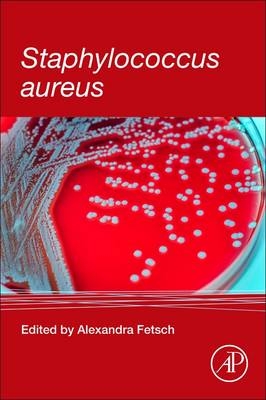
Staphylococcus aureus
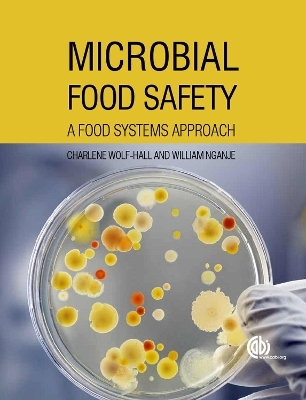
Microbial Food Safety

Buch | Hardcover
2017
|
Nova Science Publishers Inc
ISBN: 9781536105919
CHF 349,95 (inkl. MwSt)
- Versand in
15-20 Tagen